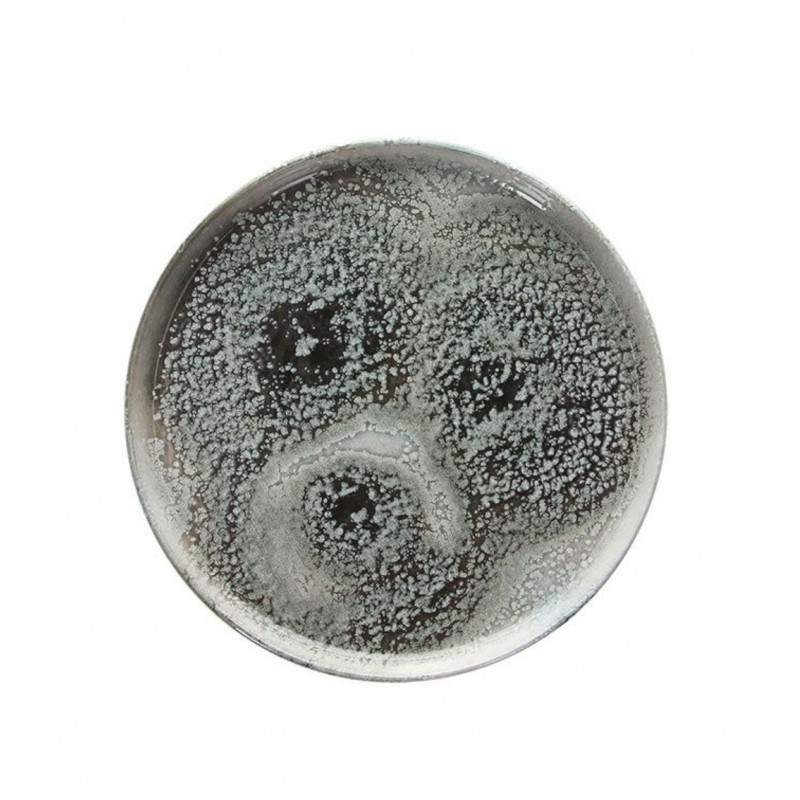
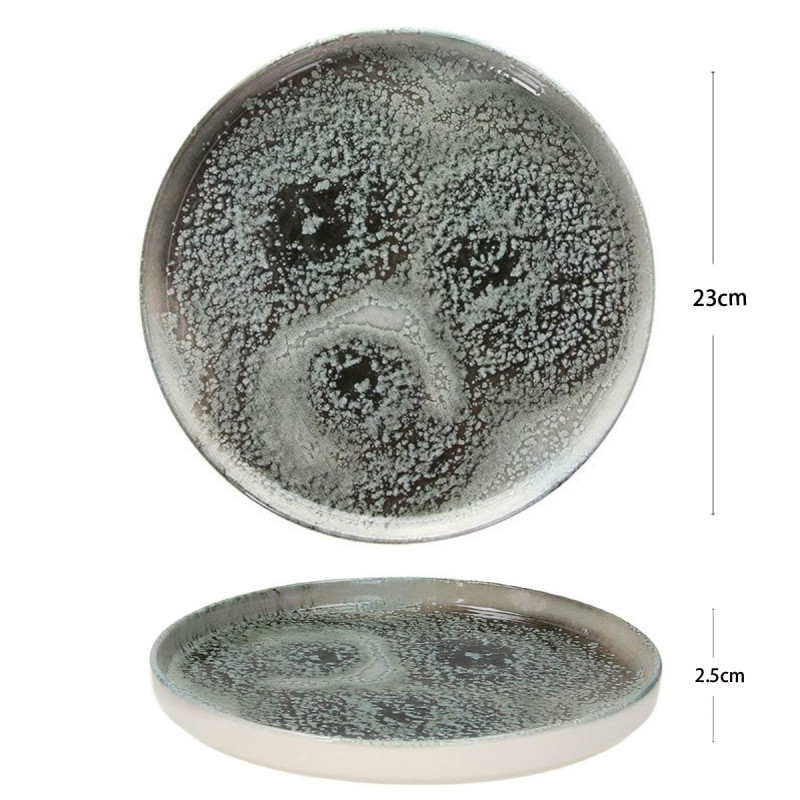
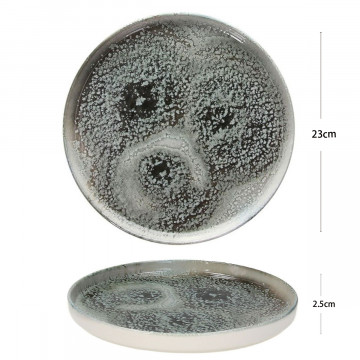

Design raffinato e colore vivace, perfetto per ristoranti e tavole di classe.
- Home
- Nuovi Arrivi add remove
-
Collezione di Piatti e Ciotole
add remove
- Monouso per la ristorazione add remove
- Prodotto Da Cucina add remove
-
Altri Prodotti
add remove
-
Offerta Speciali
add remove
PIATTO EDGE 23CM ATTITUDE ICELAND
9,90 €
Tasse escluse
 Pagamenti su conferma d’ordine
Pagamenti su conferma d’ordine
Paghi solo dopo conferma: link sicuro o bonifico. Dati protett
 Spedizione su conferma d’ordine
Spedizione su conferma d’ordine
Spedizione su conferma d’ordine Dopo l’ordine ti contattiamo per tempi
Edge plate
Main material : Porcelain/Porcellana
Width/Larghezza: cm 23
HeighAlto : cm 1,50
AT001238090
20 Articoli
Altri prodotti
16 altri prodotti della stessa categoria:
Availability: 20 In Stock
Availability: 28 In Stock
Elegante piatto ovale in ceramica smaltata blu zaffiro, ideale per servire antipasti, sushi o dolci. Design raffinato della collezione Churchill Envisage.
Availability: 28 In Stock
Elegante piatto ovale piano della collezione Blueport, realizzato in ceramica blu con finitura sfumata. Ideale per servire antipasti, sushi o piatti principali.
Availability: 100 In Stock
Piatto frutta in porcellana della serie Lagoon, con finitura verde acqua e bordo sottile brunito. Perfetto per servire frutta, dessert o antipasti con eleganza naturale.